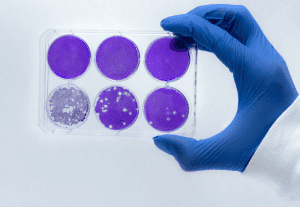
clinical_trial_4

Boston Scientific hires new director
pharmafile | March 10, 2014 | Appointment | Manufacturing and Production, Medical Communications, Research and Development, Sales and Marketing | boston scientific, ludwig
Medical device development firm Boston Scientific has elected Edward Ludwig as a director.
Ludwig was formerly the chief executive, president and chairman of the board of directors at fellow US-based medical technology firm Becton Dickinson.
Ludwig currently serves as lead director on Aetna’s board and chairs its finance committee and is also a member of the board at Xylem. He serves on the Columbia Business School board of Overseers and is the vice chairman of the Hackensack University Medical Center Network Board of Trustees.
“Ed is an accomplished business leader and brings a wealth of experience and management insight to our board,” said Pete Nicholas, Boston Scientific’s chairman. “We look forward to his perspectives and insights, and are delighted to welcome him to the board.”
Related Content
Clinical trials initiated for novel immunotherapy combo for ovarian cancer
A cross collaboration between industry and not-for-profit organisations will see Ludwig Cancer Research and the …
US cancer research receives $540 million
Six facilities in the US have received a total of $540 million from the estate …






